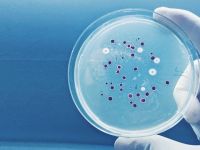
Umut veren araştırma: Yeni bir antibiyotik familyası keşfedildi

MANŞETLER
 "SAĞLIK HİZMETİ LÜTUF DEĞİL, ANAYASAL HAKTIR"
"SAĞLIK HİZMETİ LÜTUF DEĞİL, ANAYASAL HAKTIR" 3 BİN KİŞİLİK HEDEFLE SAĞLIK TARAMALARI BAŞLADI
3 BİN KİŞİLİK HEDEFLE SAĞLIK TARAMALARI BAŞLADI "TEMEL SAĞLIK HİZMETLERİ DAİRESİ BAŞHEKİMSİZ YÖNETİLEMEZ"
"TEMEL SAĞLIK HİZMETLERİ DAİRESİ BAŞHEKİMSİZ YÖNETİLEMEZ" "NÜFUSA GÖRE TARAMA ORANI YÜZDE 8’İN ALTINDA"
"NÜFUSA GÖRE TARAMA ORANI YÜZDE 8’İN ALTINDA" TABİPLER BİRLİĞİ: HASTA GÜVENLİĞİ İNSANİ VE ETİK BİR ZORUNLULUKTUR
TABİPLER BİRLİĞİ: HASTA GÜVENLİĞİ İNSANİ VE ETİK BİR ZORUNLULUKTUR LEFKOŞA DEVLET HASTANESİ’NDE BİR YAPAY KALP AMELİYATINA DAHA İMZA ATILDI
LEFKOŞA DEVLET HASTANESİ’NDE BİR YAPAY KALP AMELİYATINA DAHA İMZA ATILDI TABİPLER BİRLİĞİ: PROSTAT KANSERİ TEDAVİSİNDE EN BELİRLEYİCİ FAKTÖR ERKEN TANI
TABİPLER BİRLİĞİ: PROSTAT KANSERİ TEDAVİSİNDE EN BELİRLEYİCİ FAKTÖR ERKEN TANI ÖZKAYALAR: LENFOMA HASTALIĞI KKTC’DE DE ARTIŞ GÖSTERDİ
ÖZKAYALAR: LENFOMA HASTALIĞI KKTC’DE DE ARTIŞ GÖSTERDİ KIBRIS’IN EN DONANIMLI ‘ROBOTİK REHABİLİTASYON MERKEZİ’ YENİBOĞAZİÇİ’NDE AÇILDI
KIBRIS’IN EN DONANIMLI ‘ROBOTİK REHABİLİTASYON MERKEZİ’ YENİBOĞAZİÇİ’NDE AÇILDI “SAĞLIKTAN TASARRUF İNSAN HAYATINDAN TASARRUFTUR”
“SAĞLIKTAN TASARRUF İNSAN HAYATINDAN TASARRUFTUR” KIBRISLI TÜRK EPİDEMİYOLOJİ UZMANI BURCU’YA FISPE ÜNVANI VERİLDİ
KIBRISLI TÜRK EPİDEMİYOLOJİ UZMANI BURCU’YA FISPE ÜNVANI VERİLDİ PROF. DR. DALKAN: ÜLKEYE GİRİŞLERDE DENETİM ŞART!
PROF. DR. DALKAN: ÜLKEYE GİRİŞLERDE DENETİM ŞART! DEĞİRMENLİK, MARAŞ VE LAPTA SAĞLIK MERKEZLERİ İÇİN İHALE SÖZLEŞMELERİ İMZALANDI
DEĞİRMENLİK, MARAŞ VE LAPTA SAĞLIK MERKEZLERİ İÇİN İHALE SÖZLEŞMELERİ İMZALANDI "KIZAMIK ENFEKSİYONU İÇİN TEDBİR ALALIM"
"KIZAMIK ENFEKSİYONU İÇİN TEDBİR ALALIM" SAVAŞAN: KKTC EV SAHİPLİĞİNDE YAPILACAK GHTF2024’Ü 170 ÜLKEYE TANITTIK
SAVAŞAN: KKTC EV SAHİPLİĞİNDE YAPILACAK GHTF2024’Ü 170 ÜLKEYE TANITTIK




fdfd.gif)